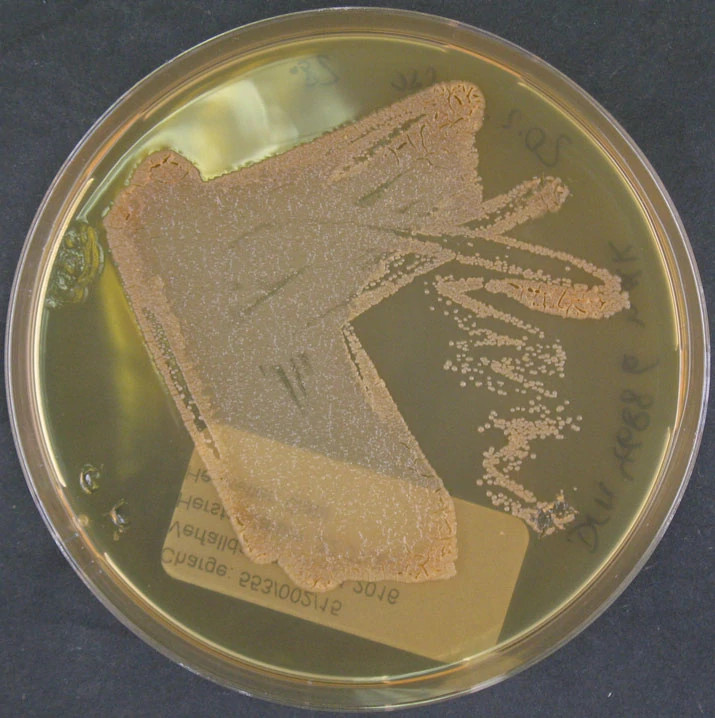
Saccharothrix ghardaiensis.jpg

Microbial Solutions
|
Ryan Cox, BS
The New Entry
Highlighting recently added microorganisms to the Accugenix® Sequence Database
 Accurate microbial identification depends entirely on whether the reference libraries behind an ID system reflect current, valid, and traceable taxonomy. Accugenix® puts massive emphasis on this alignment for several reasons that directly impact QC labs, contamination investigations, EM trending, and regulatory compliance. You can find information about Accugenix® libraries and reporting here. As new bacterial and fungal species are described daily in peer‑reviewed journals such as IJSEM and Systematic and Applied Microbiology, proper review, integration of new species, and updated nomenclature of Accugenix® library entries is paramount in keeping the database both current and relevant to customers’ identification needs. In the ever-living world of microbiology, Accugenix®’s Microbial Databases & Technology Transfer team recently added these microorganisms to join a library of over 14,000 species – all with their own unique story.
Accurate microbial identification depends entirely on whether the reference libraries behind an ID system reflect current, valid, and traceable taxonomy. Accugenix® puts massive emphasis on this alignment for several reasons that directly impact QC labs, contamination investigations, EM trending, and regulatory compliance. You can find information about Accugenix® libraries and reporting here. As new bacterial and fungal species are described daily in peer‑reviewed journals such as IJSEM and Systematic and Applied Microbiology, proper review, integration of new species, and updated nomenclature of Accugenix® library entries is paramount in keeping the database both current and relevant to customers’ identification needs. In the ever-living world of microbiology, Accugenix®’s Microbial Databases & Technology Transfer team recently added these microorganisms to join a library of over 14,000 species – all with their own unique story.
Cyanoporus fuligo

This visually striking mold was originally described from Sri Lanka on dead palm. As the name of this organism suggests, cyano‑ comes from Greek origin meaning dark blue or blue-green while ‑porus represents pore or an opening/passage. Meanwhile, fuligo comes directly from Latin describing physical similarity to soot. Wood-decaying fungi such as this play critical roles in their ecosystems, breaking down wood into soil effectively regulating the carbon cycle; and supporting the biodiversity of their natural habitat.
Saccharothrix ghardaiensis
The name Saccharothrix ghardaiensis (image left) comes from Greek words meaning sugar (saccharo) and hair (-thrix) , describing a thread‑like bacterium while ghardaiensis means ‘from Ghardaïa,’ the region in Algeria where the organism was originally discovered. As described in this organism’s original paper, “Extreme and underexplored ecosystems, such as Saharan, soils and marine sediments, are rich sources of novel, taxa belonging to Actinobacteria, some of which are, potentially good producers of interesting novel natural, bioactive compounds, notably antibiotics.”
Sphingomonas cannabina

The name Sphingomonas cannabina comes from Sphingomonas, a genus whose name refers to bacteria containing sphingosine - a vital bioactive lipid and key-player in providing antimicrobial defense and cell signaling/regulation - (from the Greek sphingos, related to sphinx plus monas meaning single unit), while cannabina reflects that this species was first isolated from the hemp plant Cannabis sativa L. ‘Cheungsam’. As originally described, this organism is a gram-negative, aerobic, rod-shaped, bacterium isolated from Cannabis sativa L. ‘Cheungsam’ in Andong, Republic of Korea. Hemp is used for medicines, food, oil, and textile fibers. Research on the microbiome of Sphingomonas cannabina has also explored its role in improving soil conditions, highlighting the potential environmental benefits of Sphingomonas cannabina in agricultural practices.
The New Entry is a column written by Charles River Next-Generation Sequencing Team Lead, Ryan Cox and is hosted by Eureka, Charles River's scientific blog. This column celebrates the microorganisms newly welcomed into the Accugenix® library. Tiny life forms with outsized scientific intrigue, each potentially carrying implications for research, industry and the continuous story of microbial discovery. See what lies beyond microbial identification.
References
1. Mao, WL., Wu, YD., Liu, HG. et al. A contribution to Porogramme (Polyporaceae, Agaricomycetes) and related genera. IMA Fungus 14, 5 (2023). https://doi.org/10.1186/s43008-023-00110-z https://doi.org/10.1186/s43008-023-00110-z
2. Bouznada K, Bouras N, Mokrane S, Chaabane Chaouch F, Zitouni A, Pötter G, Spröer C, Klenk HP, Sabaou N. Saccharothrix ghardaiensis sp. nov., an actinobacterium isolated from Saharan soil. Antonie Van Leeuwenhoek. 2017 Mar;110(3):399-405. doi: 10.1007/s10482-016-0812-4. Epub 2016 Dec 3. PMID: 27915411.
3. 5. Meklat, A., Bouras, N., Zitouni, A. et al. Saccharopolyspora ghardaiensis sp. nov., an extremely halophilic actinomycete isolated from Algerian Saharan soil. J Antibiot 67, 299–303 (2014). https://doi.org/10.1038/ja.2013.136
4. Saccharothrix Ghardaiensis MB46 | Type Strain | DSM 46886, CECT 9046 | BacDiveID:132872, bacdive.dsmz.de/strain/132872. Accessed 6 Feb. 2026.
5. Jeon D, Jiang L, Peng Y, Seo J, Li Z, Park SH, Jeong RD, Park SJ, Jeong JC, Lee J. Sphingomonas cannabina sp. nov., isolated from Cannabis sativa L. 'Cheungsam'. Int J Syst Evol Microbiol. 2022 Oct;72(10). doi: 10.1099/ijsem.0.005566. PMID: 36260506.
6. “Sphingomonas Cannabina.” Germ AI, www.germai.app/app/wiki/S;Sphingomonas%20cannabina. Accessed 6 Feb. 2026.

